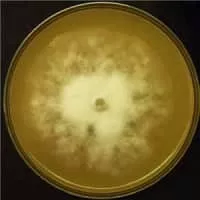

Phytophthora Sojae
| Use attributes for filter ! | |
| Scientific name | Phytophthora sojae |
|---|---|
| Rank | Species |
| Higher classification | Phytophthora |
| Phylum | Heterokontophyta |
| Date of Reg. | |
| Date of Upd. | |
| ID | 986223 |
About Phytophthora Sojae
Phytophthora sojae is an oomycete and a soil-borne plant pathogen that causes stem and root rot of soybean. This is a prevalent disease in most soybean growing regions, and a major cause of crop loss. In wet conditions the pathogen produces zoospores that move in water and are attracted to soybean roots.